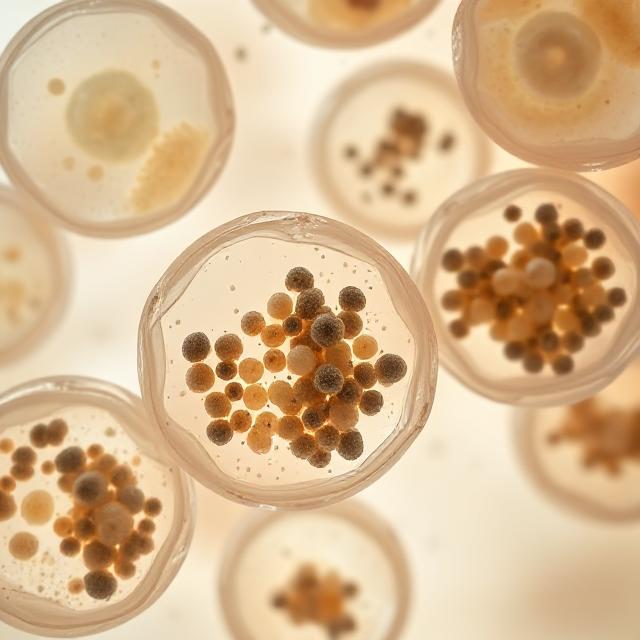

ТВОЯТА 90-ДНЕВНА ТРАНСФОРМАЦИЯ ЗА ДЪЛГОЛЕТИЕ

Тялото започва да се адаптира и да реагира. Енергията през деня става по-стабилна. Концентрацията се изостря, а умствената яснота се увеличава. Възстановяването след стрес или физическо натоварване се ускорява. Митохондриите(енергийните централи на вашите клетки) започват да произвеждат енергия по-ефективно, което носи повече устойчивост през деня. Храносмилането също се оптимизира, подпомагайки по-доброто усвояване на хранителните вещества.

Тялото започва да се усеща по-силно и по-балансирано с всеки изминал ден. Клетъчните защитни механизми се засилват. Антиоксидантите и растителните съединения намаляват оксидативния стрес и подпомагат елиминирането на по-стари и неефективни клетки. Сънят става по-дълбок и възстановяващ, което засилва регенерацията, фокуса и емоционалния баланс през деня. Възпалението и умората намаляват. Настроението, концентрацията и устойчивостта продължават да се подобряват, което е ясен знак, че тялото вече работи върху по-здрава и чиста клетъчна основа

Тук трансформацията става видима. Кожата изглежда по-чиста и здрава. Възпаленията намаляват. Ежедневната енергия и устойчивост се стабилизират на по-високо ниво. Сънят остава дълбок и възстановяващ. Имунната система и процесите на регенерация се засилват осезаемо. На този етап клетъчното обновяване и процесите, свързани с дълголетието, вече са напълно активирани, изграждайки дългосрочна основа за сила, здраве и устойчивост, която продължава да се развива с постоянен прием.
ЗАЩО СТАРЕЕМ?
Признак 1: Геномна Нестабилност

Увреждането на ДНК се натрупва ежедневно от оксидативен стрес и ускорява стареенето.
Как съставките на Nucleo Greens помагат?
Витамин С, Витамин Е, Цинк, Хидрокситирозол, Богат на Полифеноли Екстракт от Грозде, Био Арония, Био Екстракт от Шипка, Екстракт от Броколи, Ресвератрол
Тези съставки осигуряват мощна антиоксидантна защита и ключова подкрепа за ензимите за възстановяване на ДНК.
Признак 2: Скъсяване на Теломерите

Теломерите се скъсяват с всяко клетъчно делене. Когато станат твърде къси, клетките спират да се делят и навлизат в процес на стареене, което ускорява стареенето на тъканите.
Как съставките на Nucleo Greens помагат?
Ресвератрол, Кверцетин, Хидрокситирозол, Екстракт от Броколи, Спермидин, Сибирски Женшен, Био Спирулина
Тези съставки спомагат за активирането на ключови пътища за дълголетие, включително сиртуините, AMPK и активността на теломеразата, поддържайки стабилността на теломерите и здравословното клетъчно обновяване.
Признак 3: Епигенетични Промени

С напредването на възрастта начинът, по който гените се включват и изключват, се променя. Това води до нарушена клетъчна функция и по-бързо стареене.
Как съставките на Nucleo Greens помагат?
Екстракт от Броколи (Сулфорафан), Ресвератрол, Кверцетин, Спермидин, Витамин В9 (5-MTHF), Витамин В12, Инозитол (В8)
Тези съставки помагат за поддържане на правилната генна регулация, подпомагат възстановяването на клетките и запазват техния млад и активен ритъм на работа.
Признак 4: Загуба на Протеостаза

Увредените и неправилно нагънати протеини се натрупват вътре в клетките, причинявайки увреждане на клетката.
Как съставките на Nucleo Greens помагат?
Спермидин, Ресвератрол, Кверцетин, R-Алфа Липоева Киселина, Био Спирулина, Екстракт от Мурсалски Чай
Тези съставки стимулират автофагията, намаляват натрупването на увредени протеини и подпомагат естествените клетъчни механизми за тяхното възстановяване.
Признак 5: Нарушено Клетъчно Разпознаване на Хранителни Вещества

С напредването на възрастта клетките губят способността си правилно да „разчитат“ сигналите от хранителните вещества и енергията (mTOR, AMPK, инсулин). Това нарушава метаболитния баланс и ускорява процеса на стареене.
Как съставките на Nucleo Greens помагат?
Ресвератрол, Кверцетин, Сибирски Женшен, R-Алфа Липоева Киселина, Инозитол (В8), Спермидин, CoQ10
Тези съединения спомагат за активирането на ключови пътища за дълголетие като AMPK и сиртуини, поддържайки оптимален метаболизъм, ефективно използване на енергията и цялостното клетъчно здраве.
Признак 6: Митохондриална Дисфункция

Митохондриите, енергийните фабрики на клетката, губят ефективност и произвеждат повече свободни радикали. Това ускорява клетъчното стареене и влошава функциите на организма.
Как съставките на Nucleo Greens помагат?
CoQ10, R-Алфа Липоева Киселина, Витамин В1, Витамин В6, Витамин В12, Био Спирулина, Био Спанак, Хидрокситирозол, Ресвератрол
Тези съставки повишават енергийния капацитет на митохондриите, оптимизират метаболизма на кислорода и предпазват клетките от оксидативно увреждане.
Клетъчно Стареене

Остарелите или увредени клетки спират да се делят, но започват да отделят възпалителни молекули, които увреждат околните здрави клетки и ускоряват стареенето.
Как съставките на Nucleo Greens помагат?
Кверцетин, Ресвератрол, Спермидин, Богат на Полифеноли Екстракт от Грозде, Хидрокситирозол, Био Екстракт от Арония
Тези съединения действат като естествени сенолитици, като помагат за изчистването на стареещите клетки, намаляват възпалението и поддържат здравословното клетъчно обновяване.
Признак 8: Изтощение на Стволовите Клетки

Стволовите клетки губят своя регенеративен капацитет, което означава, че тъканите не могат да се възстановяват или обновяват толкова ефективно.
Как съставките на Nucleo Greens помагат?
Спермидин, Сибирски Женшен, Био Спирулина, Хидрокситирозол, Ресвератрол, Витамин D3, Цинк
Тези съставки стимулират обновяването на стволовите клетки, подпомагат регенерацията на тъканите и засилват дългосрочната клетъчна устойчивост.
Признак 9: Променена Междуклетъчна Комуникация

Клетките и органите спират да комуникират правилно. Това причинява възпаление.
Как съставките на Nucleo Greens помагат?
Ресвератрол, Кверцетин, Хидрокситирозол, Сибирски Женшен, Витамини D3 и В Комплекс, Био Арония, Мурсалски Чай
Тези съставки възстановяват ефективната клетъчна комуникация, подпомагат хормоналния баланс и подобряват синхрона между органите в тялото.
Признак 10: Хронично Възпаление

С напредването на възрастта лекото, но постоянно възпаление става хронично, което води до увреждане на клетките и тъканите.
Как съставките на Nucleo Greens помагат?
Витамин С, Витамин Е, Кверцетин, Ресвератрол, Хидрокситирозол, Цинк, Био Арония, Екстракт от Шипка, Екстракт от Броколи, Мурсалски Чай
Тези съставки подпомагат естествените противовъзпалителни процеси, като гарантират, че възпалението се активира само когато е необходимо и не уврежда здравите тъкани.
Признак 11: Дезактивирана Макроавтофагия

С напредването на възрастта клетките постепенно губят способността си да рециклират и отстраняват увредените си компоненти чрез автофагия. Това води до натрупване на клетъчни отпадъци и забавено възстановяване.
Как съставките на Nucleo Greens помагат?
Спермидин, Ресвератрол, Кверцетин, R-Алфа Липоева Киселина, Био Спирулина, Зелени Фитонютриенти
Тези съединения активират автофагията и митофагията, естествените системи за клетъчно почистване и обновяване. Те задействат AMPK, ключовия път за дълголетие, който възстановява енергийния баланс и подобрява възстановителните процеси.
Признак 12: Дисбиоза

С времето балансът в чревния микробиом се нарушава, полезните бактерии намаляват, а вредните се размножават. Това отслабва имунитета, нарушава метаболизма и засилва възпалителните процеси.
Как съставките на Nucleo Greens помагат?
Пробиотична Смес, GOFOS Пребиотик, L-Глутамин, Био Бананов Прах, Био Арония, Лиофилизирана Вишна, Био Спанак, Прах от Шипка
Тези съставки възстановяват микробния баланс, укрепват защитната бариера на червата и поддържат стабилен имунитет.
Признак 1: Геномна Нестабилност

Увреждането на ДНК се натрупва ежедневно от оксидативен стрес и ускорява стареенето.
Как съставките на Nucleo Greens помагат?
Витамин С, Витамин Е, Цинк, Хидрокситирозол, Богат на Полифеноли Екстракт от Грозде, Био Арония, Био Екстракт от Шипка, Екстракт от Броколи, Ресвератрол
Тези съставки осигуряват мощна антиоксидантна защита и ключова подкрепа за ензимите за възстановяване на ДНК.
Признак 2: Скъсяване на Теломерите

Теломерите се скъсяват с всяко клетъчно делене. Когато станат твърде къси, клетките спират да се делят и навлизат в процес на стареене, което ускорява стареенето на тъканите.
Как съставките на Nucleo Greens помагат?
Ресвератрол, Кверцетин, Хидрокситирозол, Екстракт от Броколи, Спермидин, Сибирски Женшен, Био Спирулина
Тези съставки спомагат за активирането на ключови пътища за дълголетие, включително сиртуините, AMPK и активността на теломеразата, поддържайки стабилността на теломерите и здравословното клетъчно обновяване.
Признак 3: Епигенетични Промени

С напредването на възрастта начинът, по който гените се включват и изключват, се променя. Това води до нарушена клетъчна функция и по-бързо стареене.
Как съставките на Nucleo Greens помагат?
Екстракт от Броколи (Сулфорафан), Ресвератрол, Кверцетин, Спермидин, Витамин В9 (5-MTHF), Витамин В12, Инозитол (В8)
Тези съставки помагат за поддържане на правилната генна регулация, подпомагат възстановяването на клетките и запазват техния млад и активен ритъм на работа.
Признак 4: Загуба на Протеостаза

Увредените и неправилно нагънати протеини се натрупват вътре в клетките, причинявайки увреждане на клетката.
Как съставките на Nucleo Greens помагат?
Спермидин, Ресвератрол, Кверцетин, R-Алфа Липоева Киселина, Био Спирулина, Екстракт от Мурсалски Чай
Тези съставки стимулират автофагията, намаляват натрупването на увредени протеини и подпомагат естествените клетъчни механизми за тяхното възстановяване.
Признак 5: Нарушено Клетъчно Разпознаване на Хранителни Вещества

С напредването на възрастта клетките губят способността си правилно да „разчитат“ сигналите от хранителните вещества и енергията (mTOR, AMPK, инсулин). Това нарушава метаболитния баланс и ускорява процеса на стареене.
Как съставките на Nucleo Greens помагат?
Ресвератрол, Кверцетин, Сибирски Женшен, R-Алфа Липоева Киселина, Инозитол (В8), Спермидин, CoQ10
Тези съединения спомагат за активирането на ключови пътища за дълголетие като AMPK и сиртуини, поддържайки оптимален метаболизъм, ефективно използване на енергията и цялостното клетъчно здраве.
Признак 6: Митохондриална Дисфункция

Митохондриите, енергийните фабрики на клетката, губят ефективност и произвеждат повече свободни радикали. Това ускорява клетъчното стареене и влошава функциите на организма.
Как съставките на Nucleo Greens помагат?
CoQ10, R-Алфа Липоева Киселина, Витамин В1, Витамин В6, Витамин В12, Био Спирулина, Био Спанак, Хидрокситирозол, Ресвератрол
Тези съставки повишават енергийния капацитет на митохондриите, оптимизират метаболизма на кислорода и предпазват клетките от оксидативно увреждане.
Клетъчно Стареене

Остарелите или увредени клетки спират да се делят, но започват да отделят възпалителни молекули, които увреждат околните здрави клетки и ускоряват стареенето.
Как съставките на Nucleo Greens помагат?
Кверцетин, Ресвератрол, Спермидин, Богат на Полифеноли Екстракт от Грозде, Хидрокситирозол, Био Екстракт от Арония
Тези съединения действат като естествени сенолитици, като помагат за изчистването на стареещите клетки, намаляват възпалението и поддържат здравословното клетъчно обновяване.
Признак 8: Изтощение на Стволовите Клетки

Стволовите клетки губят своя регенеративен капацитет, което означава, че тъканите не могат да се възстановяват или обновяват толкова ефективно.
Как съставките на Nucleo Greens помагат?
Спермидин, Сибирски Женшен, Био Спирулина, Хидрокситирозол, Ресвератрол, Витамин D3, Цинк
Тези съставки стимулират обновяването на стволовите клетки, подпомагат регенерацията на тъканите и засилват дългосрочната клетъчна устойчивост.
Признак 9: Променена Междуклетъчна Комуникация

Клетките и органите спират да комуникират правилно. Това причинява възпаление.
Как съставките на Nucleo Greens помагат?
Ресвератрол, Кверцетин, Хидрокситирозол, Сибирски Женшен, Витамини D3 и В Комплекс, Био Арония, Мурсалски Чай
Тези съставки възстановяват ефективната клетъчна комуникация, подпомагат хормоналния баланс и подобряват синхрона между органите в тялото.
Признак 10: Хронично Възпаление

С напредването на възрастта лекото, но постоянно възпаление става хронично, което води до увреждане на клетките и тъканите.
Как съставките на Nucleo Greens помагат?
Витамин С, Витамин Е, Кверцетин, Ресвератрол, Хидрокситирозол, Цинк, Био Арония, Екстракт от Шипка, Екстракт от Броколи, Мурсалски Чай
Тези съставки подпомагат естествените противовъзпалителни процеси, като гарантират, че възпалението се активира само когато е необходимо и не уврежда здравите тъкани.
Признак 11: Дезактивирана Макроавтофагия
С напредването на възрастта клетките постепенно губят способността си да рециклират и отстраняват увредените си компоненти чрез автофагия. Това води до натрупване на клетъчни отпадъци и забавено възстановяване.
Как съставките на Nucleo Greens помагат?
Спермидин, Ресвератрол, Кверцетин, R-Алфа Липоева Киселина, Био Спирулина, Зелени Фитонютриенти
Тези съединения активират автофагията и митофагията, естествените системи за клетъчно почистване и обновяване. Те задействат AMPK, ключовия път за дълголетие, който възстановява енергийния баланс и подобрява възстановителните процеси.
Признак 12: Дисбиоза

С времето балансът в чревния микробиом се нарушава, полезните бактерии намаляват, а вредните се размножават. Това отслабва имунитета, нарушава метаболизма и засилва възпалителните процеси.
Как съставките на Nucleo Greens помагат?
Пробиотична Смес, GOFOS Пребиотик, L-Глутамин, Био Бананов Прах, Био Арония, Лиофилизирана Вишна, Био Спанак, Прах от Шипка
Тези съставки възстановяват микробния баланс, укрепват защитната бариера на червата и поддържат стабилен имунитет.
Сертифицирано качество
Нашите продукти са стриктно тествани и сертифицирани и се считат за еталон за високи постижения в здравето и благосъстоянието. Изберете с увереност, защото вашето благополучие е наш основен приоритет.
КАКВО КАЗВАТ ЕКСПЕРТИТЕ ЗА NUCLEO GREENS

КАКВО КАЗВАТ НАШИТЕ КЛИЕНТИ






Omega 3
Получавате автоматично безплатен подарък с Вашата поръчка
 30-дневна гаранция за връщане на парите
30-дневна гаранция за връщане на парите

Върни Часовника Назад
Nucleo Greens е цялостна формула за дълголетие, създадена да работи там, където стареенето реално започва - на клетъчно ниво. 100% натурална, с подбрани активни съставки с доказано действие. Nucleo Greens работи директно върху 12-те ключови механизма, свързани със стареенето, като подава на тялото точните биологични сигнали, които то губи с времето. (Научете повече за 12-те механизма на стареенето)
ЗАБАВИ СТАРЕЕНЕТО. ДАЙ ШАНС НА ТЯЛОТО ДА СЕ ОБНОВЯВА:
Как го постигаме:
- Nucleo Greens подпомага естественото прочистване и регенерация на клетките (Автофагия).
Вие ще усетите: По-добра концентрация и намаляване на мозъчната мъгла. По-бързо възстановяване и по-добър външен вид. Всичко това са ежедневни доказателства, че процесите на стареене са забавени.
- Повишава клетъчната енергия чрез активиране на митохондриите:
Вие ще усетите: Постоянна енергия през целия ден, без познатия срив следобед. По-лесно справяне с дълги работни часове, интензивни тренировки или неочаквани предизвикателства.
- Обновява тъканите и защитава ДНК-то:
Вие ще усетите: По-бързо заздравяване, кожата се възстановява по-бързо, а мускулите регенерират по-ефективно след натоварване. Кожата Ви е по-чиста, стегната и устойчива - видим знак, че стареенето е забавено.
ДОПЪЛНИТЕЛНИ ПОЛЗИ ОТ ПРИЕМА НА NUCLEO GREENS:
Чревно здраве за силен имунитет - защото здравето започва отвътре. Nucleo Greens поддържа баланса на чревната микрофлора. Подобрява усвояването на хранителните вещества. Ускорява възстановяването и укрепва естествените защитни механизми на организма.
Мозъчно здраве и здраво сърце - Подпомага концентрацията, паметта и умствената яснота. Активира автофагията (това е естествения процес, в организма при който клетките се самопочистват от отпадъци и повредени части) за по-здрави кръвоносни съдове и стабилна сърдечна функция.
По-дълбок и възстановяващ сън - Наслади се на спокоен, дълбок сън и по-пълноценно нощно възстановяване. Nucleo Greens подпомага естествените процеси на регенерация, така че да се събуждаш отпочинал и с повече енергия.
Сияйна кожа - Подпомага баланса на чревната флора, намалява възпаленията и активира естествената детоксикация на клетките за по-гладка, чиста и сияйна кожа.
Съставки
Съставки
Комбинация от мощни активатори за митохондриите (енергийните централи на клетките), клетъчни биоактивни хранителни вещества и елитни зелени суперхрани, подбрани, за да възстановят енергията, концентрацията и устойчивостта на тялото, директно от източника: твоите клетки.
Какво всъщност представлява Nucleo Greens?
Какво всъщност представлява Nucleo Greens?
Nucleo Greens е научно разработена формула за дълголетие, създадена да подпомага 12-те основни механизма на стареене чрез естествени активни съставки с клинично доказано действие, подкрепени от научни проучвания.
Всяко съединение е внимателно подбрано заради ролята си в поддържането на дългосрочна жизненост и устойчивост на клетъчно ниво.
Как действа:
- Активира клетъчния детокс – подпомага изчистването на увредени компоненти и възстановява енергийния баланс.
- Забавя клетъчното стареене – стимулира естествените процеси на клетъчно прочистване и подмладяване.
- Подкрепя клетъчната регенерация – насърчава обновяването на клетките, които се износват по-бързо с възрастта.
- Защитава ДНК-то – предпазва клетките от оксидативни увреждания, свързани с напредването на възрастта.
С времето този постоянен клетъчен поддържащ ефект изгражда здрава основа за по-добро, по-бавно и по-здравословно остаряване, измерено не само в години, а в това колко добре се чувстваш всеки ден и колко устойчиво реагира тялото ти на времето.
Кога ще усетя ефект?
Кога ще усетя ефект?
Защитата и възстановяването на митохондриите е постепенен процес, който изисква време и постоянство. Докато дълбоките, дългосрочни ползи за здравословното стареене се натрупват в продължение на седмици и месеци, можете да очаквате да усетите положителни ефекти много по-рано:
- Дни 3–5 : Забележимо по-стабилна енергия, подобрено храносмилане и по-остър фокус
- Седмици 2–4 : Намалени енергийни спадове, по-балансирано настроение, по-бързо възстановяване след стрес или тренировка
- Седмици 4–8 : По-дълбок, по-възстановителен сън, по-чиста кожа, по-малко възпаление и по-силна обща дневна база
Като поддържате митохондриите си постоянно, вие помагате на клетките си да произвеждат чиста, трайна енергия и полагате основите за по-здравословно стареене отвътре навън.









Ползите от Nucleo Greens
ЗАПОЧНИ ПРОМЯНАТА СЕГА
Ползите от Nucleo Greens
-
Забавя стареенето — активира естествения процес на вътрешно клетъчно почистване.
-
Клетъчна енергия — устойчива енергия през целия ден.
-
Засилва паметта и концентрацията — поддържа мозъчната функция
-
По-силен имунитет — укрепва защитата срещу стресови фактори
-
Детокс и чревен баланс — подобрява храносмилането и възстановява микробиома.
-
Бързо възстановяване — ускорява клетъчното обновяване и намалява умората
Защо Nucleo Greens е Различен
Създаден с точно това, от което тялото ти се нуждае и нищо излишно. Съставки с клинично доказано действие, подкрепени от научни проучвания.





Истински въпроси. Истински проблеми. Истински решения.
Какво всъщност представлява Nucleo Greens?
Какво всъщност представлява Nucleo Greens?
Nucleo Greens е научно разработена формула за дълголетие, създадена да подпомага 12-те основни механизма на стареене чрез естествени активни съставки с клинично доказано действие, подкрепени от научни проучвания.
Всяко съединение е внимателно подбрано заради ролята си в поддържането на дългосрочна жизненост и устойчивост на клетъчно ниво.
Как действа:
- Активира клетъчния детокс – подпомага изчистването на увредени компоненти и възстановява енергийния баланс.
- Забавя клетъчното стареене – стимулира естествените процеси на клетъчно прочистване и подмладяване.
- Подкрепя клетъчната регенерация – насърчава обновяването на клетките, които се износват по-бързо с възрастта.
- Защитава ДНК-то – предпазва клетките от оксидативни увреждания, свързани с напредването на възрастта.
С времето този постоянен клетъчен поддържащ ефект изгражда здрава основа за по-добро, по-бавно и по-здравословно остаряване, измерено не само в години, а в това колко добре се чувстваш всеки ден и колко устойчиво реагира тялото ти на времето.
Чувствам се уморен, отпаднал и постоянно възпален. Може ли да помогне?
Чувствам се уморен, отпаднал и постоянно възпален. Може ли да помогне?
Да, точно за това е създаден Nucleo Greens.
Възстановява естествения баланс на тялото: чиста енергия, по-ясна концентрация, по-добро храносмилане и по-ниски нива на възпаление, отвътре навън.
Формулата таргетира митохондриите, червата и системите за детоксикация, там, където умората и хроничното възпаление реално започват.
Защо Nucleo Greens е по-добър от останалите?
Защо Nucleo Greens е по-добър от останалите?
Защото не гоним трендове. Грижим се за реални резултати.
- Само активни съставки — без консерванти, изкуствени оцветители или излишни пълнители. Научно доказани съставки - не просто съставки.
- Висока бионаличност — тялото наистина ги усвоява.
- Без ГМО, Био, Веган, Без глутен, Без алергени.
Тестване за чистота и ефективност. Без компромиси. Гарантирана чистота. Всяка партида преминава през строги тестове, които покриват световните стандарти за безопасност:
- Тест за тежки метали
- Потвърдена идентичност и сила на активните съставки
- Проверка за микробни и екологични замърсители
Как се приема?
Как се приема?
Една мерителна лъжичка (5 g) на ден.
Смеси с чаша студена вода или добави в смути по избор.
Безопасно ли е за дългосрочен прием?
Безопасно ли е за дългосрочен прием?
Да, формулата е създадена за ежедневен и дългосрочен прием. Всички съставки са с доказан профил на безопасност и подкрепени с клинични проучвания. Без изкуствени добавки. Без синтетика. Само чиста, естествена подкрепа за тялото.
Мога ли да го приемам с други добавки?
Мога ли да го приемам с други добавки?
Да, Nucleo Greens е подходящ за комбиниране и се съчетава добре с повечето режими на хранителни добавки. Ако приемате лекарства с рецепта, препоръчваме да се консултирате с Вашия лекар като стандартна предпазна мярка.
Ами ако вече се храня здравословно и се грижа за себе си?
Ами ако вече се храня здравословно и се грижа за себе си?
Точно затова ще усетите разликата. Дори при чиста, богата на хранителни вещества диета, много микроелементи, полифеноли и кофактори липсват, което ограничава клетъчната устойчивост. Nucleo Greens не само запълва тези празнини, но и усилва ползите от съществуващите ви здравословни навици. Не е заместител на балансираната диета.
АКТИВЕН. НАТУРАЛЕН. МОЩЕН.

Един от най-мощните антиоксиданти, над 100 пъти по-силен от витамин C. Помага за защита на клетките от оксидативен стрес и подпомага здравословното стареене, сърдечното здраве и ежедневното клетъчно възстановяване.

Натурален сенолитик, който подпомага изчистването на стари (неефективни) клетки и намалява хроничното възпаление. Подкрепя имунната устойчивост и дългосрочното клетъчно здраве.

Подпомага активирането на сиртуините, гените свързани с клетъчното възстановяване и здравословното стареене. Известен с ролята си в изследванията на дълголетието, тази съставка помага на тялото да запази своята устойчивост във времето.

Богат на антиоксиданти, естествени ноотропици и важни микроелементи. Концентриран източник на растителна, органична храна, създаден да подпомага енергията, мозъчното здраве и клетъчния баланс, по начини, които ежедневното хранене трудно осигурява..

Суперплод с изключително високо съдържание на антиоксиданти, естествено богат на антоцианини и полифеноли. Подпомага естествената способност на тялото да защитава и възстановява клетките, засилвайки клетъчната устойчивост и общото благосъстояние. Концентрирана форма, създадена за извличане на активните съединения с най-силен ефект.

Естествен източник на мелатонин, антоцианини и съединения, подпомагащи възстановяването. Работи синергично, за да засили клетъчния ремонт и да подкрепи възстановителните процеси по време на сън и почивка.

Един от най-мощните антиоксиданти, над 100 пъти по-силен от витамин C. Помага за защита на клетките от оксидативен стрес и подпомага здравословното стареене, сърдечното здраве и ежедневното клетъчно възстановяване.

Натурален сенолитик, който подпомага изчистването на стари (неефективни) клетки и намалява хроничното възпаление. Подкрепя имунната устойчивост и дългосрочното клетъчно здраве.

Подпомага активирането на сиртуините, гените свързани с клетъчното възстановяване и здравословното стареене. Известен с ролята си в изследванията на дълголетието, тази съставка помага на тялото да запази своята устойчивост във времето.

Богат на антиоксиданти, естествени ноотропици и важни микроелементи. Концентриран източник на растителна, органична храна, създаден да подпомага енергията, мозъчното здраве и клетъчния баланс, по начини, които ежедневното хранене трудно осигурява..

Суперплод с изключително високо съдържание на антиоксиданти, естествено богат на антоцианини и полифеноли. Подпомага естествената способност на тялото да защитава и възстановява клетките, засилвайки клетъчната устойчивост и общото благосъстояние. Концентрирана форма, създадена за извличане на активните съединения с най-силен ефект.

Естествен източник на мелатонин, антоцианини и съединения, подпомагащи възстановяването. Работи синергично, за да засили клетъчния ремонт и да подкрепи възстановителните процеси по време на сън и почивка.
























